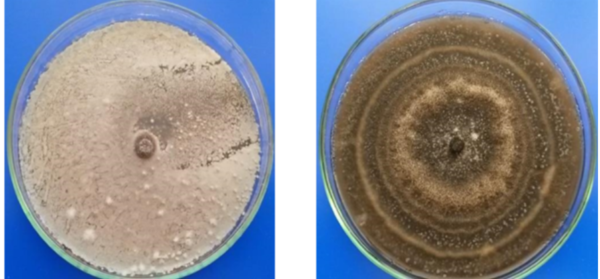

Está compuesto por un alga, nutrientes y una bacteria antagonista de los patógenos.
La multinacional Compo Expert se apresta a lanzar un nuevo bioestimulante que no solo permitirá fortalecer el desarrollo de los cultivos, sino que además tendrá la característica de ayudar al crecimiento de las plantas. Este crecimiento está dado por la presencia de la bacteria que compite con los patógenos del suelo por el sustrato en la Rizosfera de las plantas.
El Gerente comercial de la compañía en Argentina, Juan Ignacio Messineo, afirmó que este nuevo producto comenzará a comercializarse entre fines de mayo y principios de junio.
Su nombre es Vitanica RZ y consiste en un abono líquido enriquecido con extracto del alga Ecklonia Máxima y con una cepa de la bacteria Bacillus amyloliquefaciens cuyo descubrimiento fue patentado por Compo Expert. Esa cepa se denomina R6-CDX®.
“Es una bacteria que permite mejorar el hábitat en que se desarrolla la planta, por medio de la producción de antibióticos del tipo Bacilysin e Iturin que son altamente fungo- tóxicos, ayudando a bajar la incidencia de enfermedades, de ahí viene el término del manejo integral Nutricional”, indicó Messineo.
Como es un bioestimulante líquido, su aplicación puede ser realizada tanto a nivel foliar, como por fertirriego a dosis recomendada según el marbete.
Efectos
De movida, al estar compuesto en un 30 por ciento por Ecklonia Máxima, Vitanica RZ es un estimulante promotor de crecimiento. “Es un alga muy rica en auxinas, lo que permite un mayor enraizamiento de las plantas y eso significa más ramas, más hojas y más granos”, remarcó Messineo.
A eso hay que añadir el aporte nutricional que suma el contenido de nitrógeno y potasio que posee este producto.
Pero, como se mencionó, su salto distintivo es la acción preventiva, gracias a estas bacterias que pueden producir compuestos capaces de competir con los patógenos.
Ensayos de laboratorio realizados por Compo Expert demostraron, por ejemplo, que la cepa descubierta logró un efecto inhibitorio, inoculando en caja de Petri hongos del complejo de suelo.
Fuente: Compo Expert